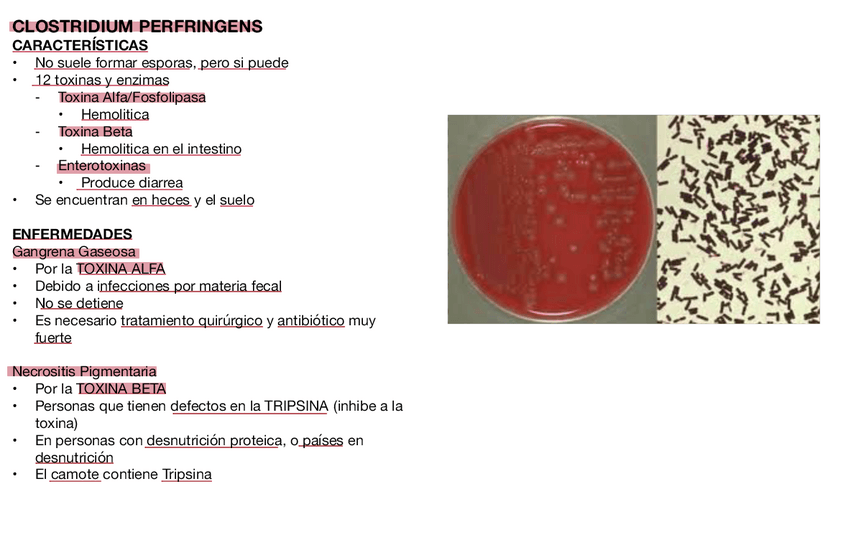

Ecología Humana
Resumen de Bacteria Neisseria bien redactado y fácil de aprender para tus clases de Ecología
apuntes
-
Eco Humana - Parte Juan Pedro
He publicado nuevos apuntes de 4º Ecología Humana: Eco Humana - Parte Juan Pedro
apuntes
-
Eco Humana - Parte Paula
He publicado nuevos apuntes de 4º Ecología Humana: Eco Humana - Parte Paula
Resumen de los microorganismos de la clase Ecología Humana (Microbiología), cada uno con la enfermedad que causa, vía de transmisión, y diagnóstico.
He publicado nuevos apuntes de 4º Ecología Humana: Ecologia-Humana-Apuntes.pdf
He publicado nuevos apuntes de 4º Ecología Humana: T.1-Seleccion-natural.pdf
He publicado nuevos apuntes de 4º Ecología Humana: T.4-Experimento-con-humanos.pdf
He publicado nuevos apuntes de 4º Ecología Humana: T.2-Rasgos-sociales.pdf
He publicado nuevos apuntes de 4º Ecología Humana: T.3-Prosocialidad-y-antisocialidad.pdf
He publicado nuevos apuntes de 3º Ecología Humana: VIRUS-RESPIRATORIOS.pdf
He publicado nuevos apuntes de 4º Ecología Humana: Apuntes-temas-1-7.pdf
He publicado nuevos apuntes de 3º Ecología Humana: GUTIERREZ-ACTIV2-00468735-50269.pdf
He publicado nuevos apuntes de 4º Ecología Humana: Modulo-2.-Temas-4-6.pdf
He publicado nuevos apuntes de 4º Ecología Humana: Modulo-1.-Tema-1-3.pdf
apuntes
-
Apuntes ecología humana
He publicado nuevos apuntes de 4º Ecología Humana: Apuntes ecología humana
He publicado nuevos apuntes de 3º Ecología Humana: ENFERMEDADES-POR-S-AUREUS.pdf
He publicado nuevos apuntes de 3º Ecología Humana: BACILLUS-GRAM-POSITIVOS.pdf
He publicado nuevos apuntes de 3º Ecología Humana: INTRODUCION-A-LA-BACTERIOLOGIA.pdf
He publicado nuevos apuntes de 3º Ecología Humana: STAPHYLOCOCCUS-AUREUS.pdf
He publicado nuevos apuntes de 3º Ecología Humana: ENFERMEDADES-POR-ESTREPTOCOCOS.pdf
He publicado nuevos apuntes de 3º Ecología Humana: INTRODUCCION-A-LA-MICROBIOLOGIA.pdf
He publicado nuevos apuntes de 3º Ecología Humana: BACTERIAS-GRAM-NEGATIVAS.pdf
He publicado nuevos trabajos de 9º Ecología Humana: ENSAYO-DE-ECOLOGIA-HUMANA.pdf
apuntes
-
Parte Juan Pedro
He publicado nuevos apuntes de 4º Ecología Humana: Parte Juan Pedro
examenes
-
EXAMEN 2021-2022
He publicado nuevos examenes de 4º Ecología Humana: EXAMEN 2021-2022
apuntes
-
TEMA 5-7
He publicado nuevos apuntes de 4º Ecología Humana: TEMA 5-7
apuntes
-
TEMA 1-4
He publicado nuevos apuntes de 4º Ecología Humana: TEMA 1-4
apuntes
-
MICROBIOLOGÍA
He publicado nuevos apuntes de 3º Ecología Humana: MICROBIOLOGÍA
apuntes
-
APUNTES 2021-2022
He publicado nuevos apuntes de 4º Ecología Humana: APUNTES 2021-2022
apuntes
-
Apuntes completos
He publicado nuevos apuntes de 4º Ecología Humana: Apuntes completos
apuntes
-
Apuntes Completos EH
He publicado nuevos apuntes de 4º Ecología Humana: Apuntes Completos EH

¡Estás al día!
Has visto todos los archivos